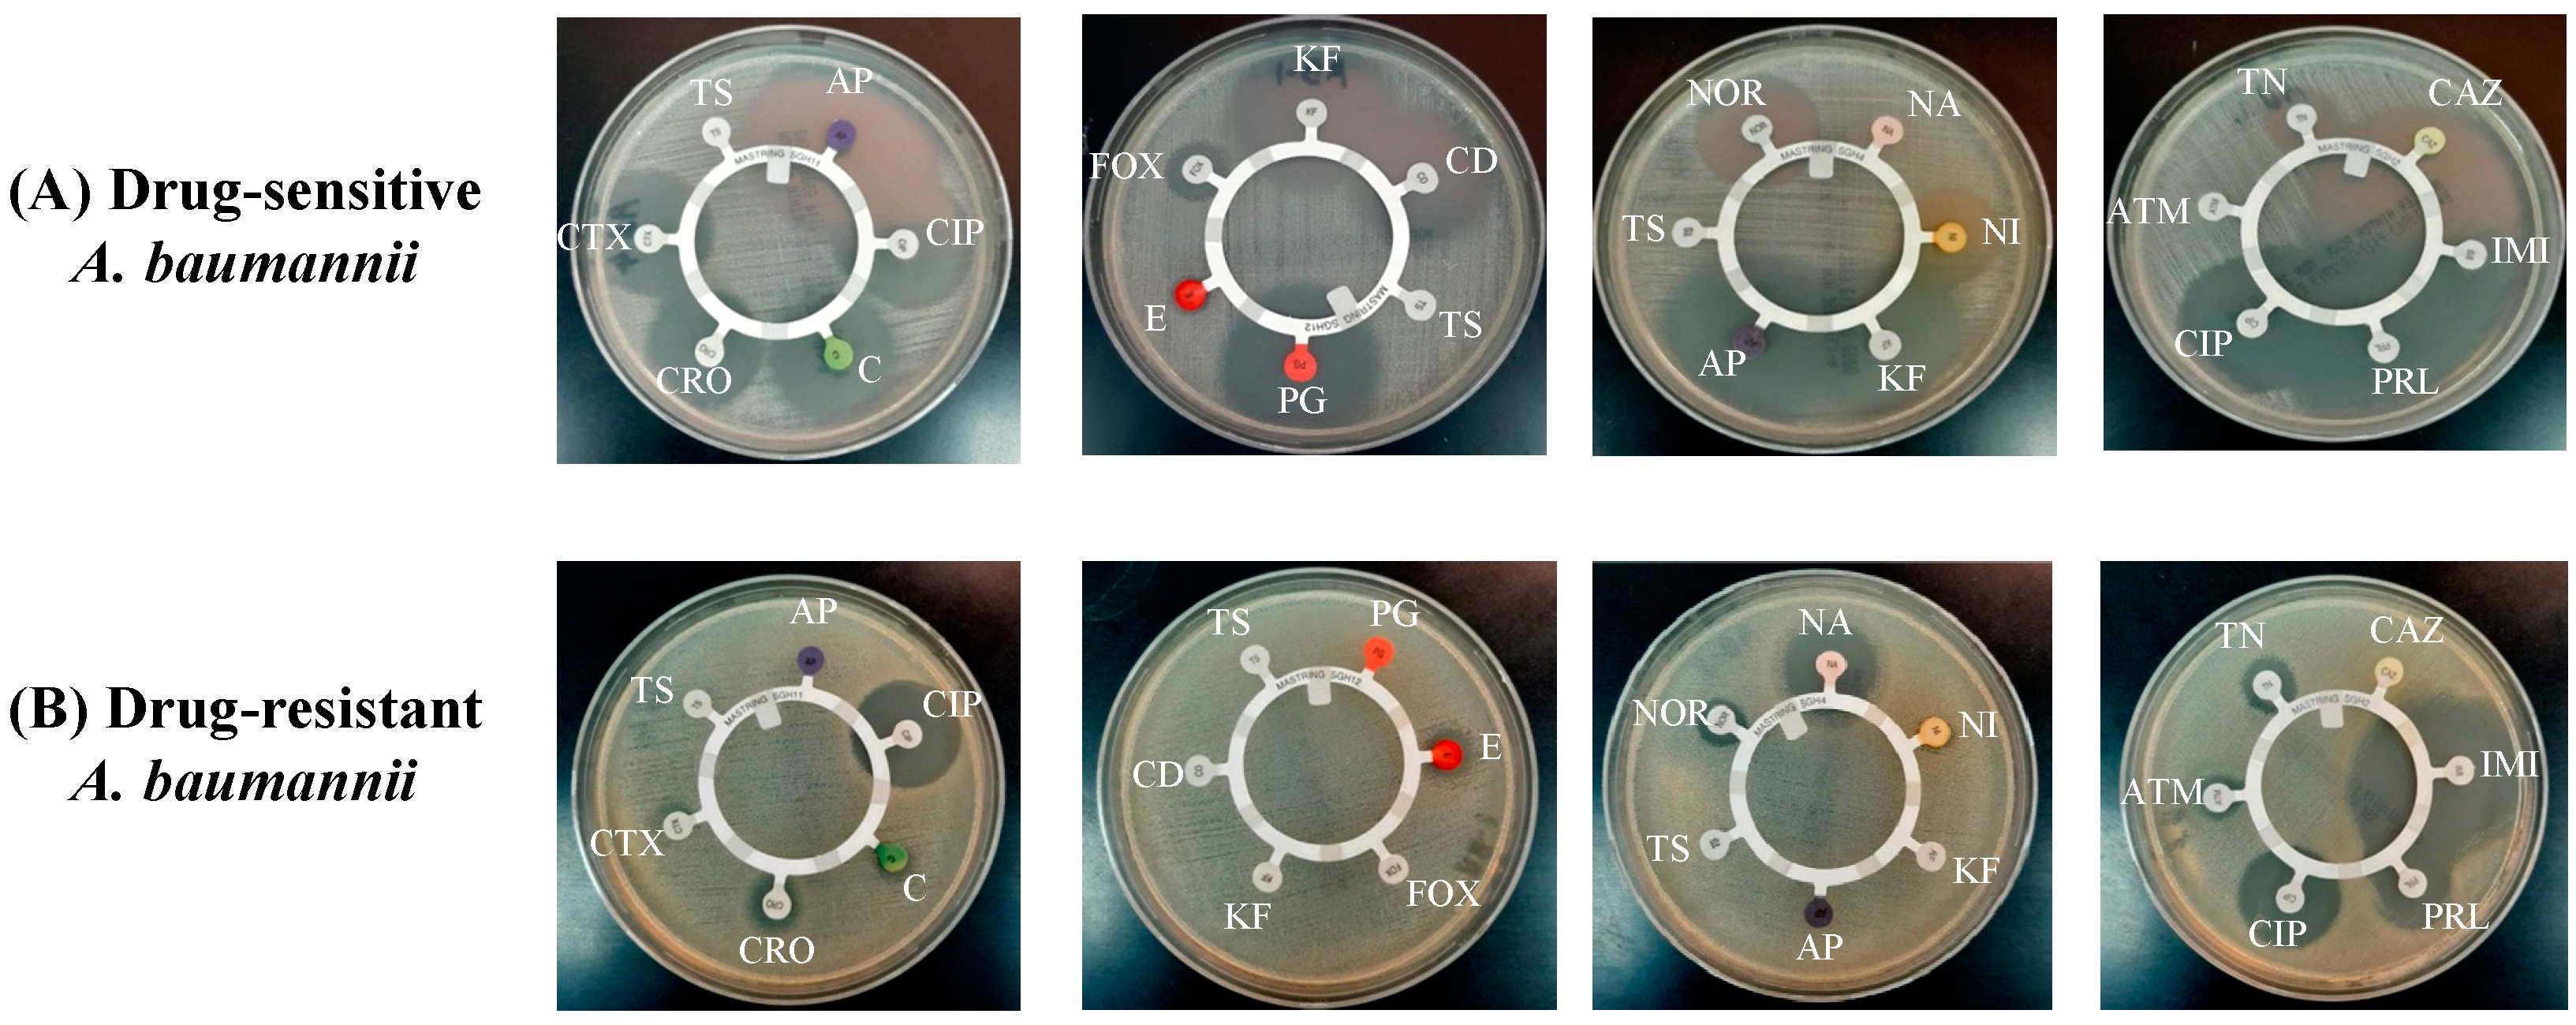
Pharmaceutics 13 00677 g002 Pharmaceutics 13 00677 g002

Safety and Therapeutic Efficacy of Thymoquinone-Loaded Liposomes against Drug-Sensitive and Drug-Resistant Acinetobacter baumannii
Abstract
1. Introduction
2. Materials and Methods
2.1. Materials
2.2. Test Strain of Acinetobacter baumannii
2.3. Screening of A. baumannii by Automated Susceptibility Testing
2.4. Determination of In Vitro Activity of TQ against A. baumannii
2.5. Time-Kill Assay
2.6. Preparation of TQ-Loaded Liposomes
2.7. Characterization of Liposomes
2.8. Determination of TQ Entrapment Efficiency (EE) in Liposomes
2.9. Determination of Stability of Liposomes and Release Kinetics of TQ
2.10. Mice
2.10.1. Determination of TQ Toxicity in Mice
- (1)
- Saline
- (2)
- Sham liposomes
- (3)
- Free TQ—1 mg/kg
- (4)
- Free TQ—10 mg/kg
- (5)
- Free TQ—20 mg/kg
- (6)
- Free TQ—40 mg/kg
- (7)
- Lip-TQ—1 mg/kg
- (8)
- Lip-TQ—10 mg/kg
- (9)
- Lip-TQ—20 mg/kg
- (10)
- Lip-TQ—40 mg/kg
2.10.2. Analysis of Hematological and Biochemical Parameters
2.10.3. Standardization of A. baumannii Infection in Mice
2.10.4. Mouse Model of A. baumannii Infection
2.10.5. Treatment of A. baumannii-Infected Mice with TQ Formulations
2.10.6. Determination of the Bacterial Load in Lung Tissues
2.10.7. Determination of Leukocytes and Inflammation Markers
2.10.8. Statistical Analyses
3. Results
3.1. Antibiotic Susceptibility Pattern of A. baumannii
3.2. In Vitro Activity of TQ against A. baumannii
3.3. Activity of TQ against the Drug-Sensitive and Drug-Resistant A. baumannii According to Time-Kill Studies
3.4. Characterization of TQ Liposomes
3.5. Stability of TQ-Encapsulated Liposomes and Release Kinetics of TQ
3.6. Administration of Free TQ or Lip-TQ Did Not Induce any Significant Toxicity
3.7. Administration of Free TQ or Lip-TQ Did Not Induce any Remarkable Changes in Hematological Parameters
3.8. Effect of Free TQ or Lip-TQ on Liver and Kidney Function Parameters
3.9. Susceptibility of Mice to Intravenous Infection by A. baumannii
3.10. Treatment with Lipsomal-TQ-Protected Mice against the Systemic Infection of Drug-Sensitive A. baumannii
3.11. Lip-TQ, but Not AMX, Was Effective in the Treatment of the Systemic Infection of Drug-Resistant A. baumannii
3.12. Treatment with Lip-TQ, Not AMX, Alleviated the Parameters of Total Leukocytes and Neutrophils in the Mice Infected with Drug-Resistant A. baumannii
3.13. Treatment with Lip-TQ, Not AMX, Alleviated the Parameters of Inflammation Markers in the Mice Infected with Drug-Resistant A. baumannii
4. Discussion
5. Conclusions
Author Contributions
Funding
Institutional Review Board Statement
Informed Consent Statement
Data Availability Statement
Acknowledgments
Conflicts of Interest
References
- Lin, M.F.; Lan, C.Y. Antimicrobial resistance in Acinetobacter baumannii: From bench to bedside. World J. Clin Cases. 2014, 2, 787–814. [Google Scholar] [CrossRef] [PubMed]
- Ibrahim, M.E. Prevalence of Acinetobacter baumannii in Saudi Arabia: Risk factors, antimicrobial resistance patterns and mechanisms of carbapenem resistance. Ann. Clin. Microbiol. Antimicrob. 2019, 18, 1. [Google Scholar] [CrossRef] [PubMed]
- World Health Organization. Central Asian and Eastern European Surveillance of Antimicrobial Resistance. Annual Report 2017; World Health Organization Regional Office for Europe: Copenhagen, Denmark, 2017. [Google Scholar]
- Aly, M.; Tayeb, H.T.; Al Johani, S.M.; Alyamani, E.J.; Aldughaishem, F.; Alabdulkarim, I.; Balkhy, H.H. Genetic diversity of OXA-51-like genes among multidrug-resistant Acinetobacter baumannii in Riyadh, Saudi Arabia. Eur. J. Clin. Microbiol. Infect Dis. 2014, 33, 1223–1228. [Google Scholar] [CrossRef] [PubMed]
- Lee, C.R.; Lee, J.H.; Park, M.; Park, K.S.; Bae, I.K.; Kim, Y.B.; Cha, C.J.; Jeong, B.C.; Lee, S.H. Biology of Acinetobacter baumannii: Pathogenesis, Antibiotic Resistance Mechanisms, and Prospective Treatment Options. Front. Cell Infect Microbiol. 2017, 7, 55. [Google Scholar] [CrossRef] [PubMed]
- Saeed, N.K.; Kambal, A.M.; El-Khizzi, N.A. Antimicrobial-resistant bacteria in a general intensive care unit in Saudi Arabia. Saudi. Med. J. 2010, 31, 1341–1349. [Google Scholar]
- Khan, M.A.; Younus, H. Thymoquinone Shows the Diverse Therapeutic Actions by Modulating Multiple Cell Signaling Pathways: Single Drug for Multiple Targets. Curr. Pharm. Biotechnol. 2018, 19, 934–945. [Google Scholar] [CrossRef]
- Rahmani, A.H.; Alzohairy, M.A.; Khan, M.A.; Aly, S.M. Therapeutic Implications of Black Seed and Its Constituent Thymoquinone in the Prevention of Cancer through Inactivation and Activation of Molecular Pathways. Evid Based Complement Alternat Med. 2014, 2014, 724658. [Google Scholar] [CrossRef]
- Khan, M.A. Thymoquinone, a constituent of prophetic medicine-black seed, is a miracle therapeutic molecule against multiple diseases. Int. J. Health Sci. 2019, 13, 1–2. [Google Scholar]
- Majdalawieh, A.F.; Fayyad, M.W. Immunomodulatory and anti-inflammatory action of Nigella sativa and thymoquinone: A comprehensive review. Int. Immunopharmacol. 2015, 28, 295–304. [Google Scholar] [CrossRef]
- Miao, X.; Liu, H.; Zheng, Y.; Guo, D.; Shi, C.; Xu, Y.; Xia, X. Inhibitory Effect of Thymoquinone on Listeria monocytogenes ATCC 19115 Biofilm Formation and Virulence Attributes Critical for Human Infection. Front. Cell Infect Microbiol. 2019, 9, 304. [Google Scholar] [CrossRef]
- Randhawa, M.A.; Gondal, M.A.; Al-Zahrani, A.H.; Rashid, S.G.; Ali, A. Synthesis, morphology and antifungal activity of nano-particulated amphotericin-B, ketoconazole, and thymoquinone against Candida albicans yeasts and Candida biofilm. J. Environ. Sci. Health A Tox. Hazard Subst. Environ. Eng. 2015, 50, 119–124. [Google Scholar] [CrossRef]
- Tantivitayakul, P.; Kaypetch, R.; Muadchiengka, T. Thymoquinone inhibits biofilm formation and virulence properties of periodontal bacteria. Arch Oral Biol. 2020, 115, 104744. [Google Scholar] [CrossRef] [PubMed]
- Paster, B.J.; Boches, S.K.; Galvin, J.L.; Ericson, R.E.; Lau, C.N.; Levanos, V.A.; Sahasrabudhe, A.; Dewhirst, F.E. Bacterial diversity in human subgingival plaque. J. Bacteriol. 2001, 183, 3770–3783. [Google Scholar]
- Khan, M.A. Antimicrobial actions of thymoquinone. In Molecular and Therapeutic Actions of Thymoquinone; Younus, H., Ed.; Springer: Berlin/Heidelberg, Germany, 2018; pp. 57–64. [Google Scholar]
- Khan, M.A. Targeted Drug Delivery Using Tuftsin-bearing Liposomes: Implications in the treatment of infectious diseases and tumors. Curr. Drug Targets. 2020, 22, 770–778. [Google Scholar] [CrossRef] [PubMed]
- Zukancic, D.; Suys, E.J.A.; Pilkington, E.H.; Algarni, A.; Al-Wassiti, H.; Truong, N.P. The Importance of Poly(ethylene glycol) and Lipid Structure in Targeted Gene Delivery to Lymph Nodes by Lipid Nanoparticles. Pharmaceutics 2020, 12, 1068. [Google Scholar] [CrossRef] [PubMed]
- Odeh, F.; Ismail, S.I.; Abu-Dahab, R.; Mahmoud, I.S.; Al Bawab, A. Thymoquinone in liposomes: A study of loading efficiency and biological activity towards breast cancer. Drug Deliv. 2012, 19, 371–377. [Google Scholar] [CrossRef] [PubMed]
- Rajput, S.; Puvvada, N.; Kumar, B.N.; Sarkar, S.; Konar, S.; Bharti, R.; Dey, G.; Mazumdar, A.; Pathak, A.; Fisher, P.B.; et al. Overcoming Akt Induced Therapeutic Resistance in Breast Cancer through siRNA and Thymoquinone Encapsulated Multilamellar Gold Niosomes. Mol. Pharm. 2015, 12, 4214–4225. [Google Scholar] [CrossRef]
- Khan, M.A.; Aljarbou, A.N.; Khan, A.; Younus, H. Liposomal thymoquinone effectively combats fluconazole-resistant Candida albicans in a murine model. Int. J. Biol. Macromol. 2015, 76, 203–208. [Google Scholar] [CrossRef] [PubMed]
- Clinical and Laboratory Standards Institute. Performance Standards for Antimicrobial Susceptibility Testing: Twenty-Sixth Informational Supplement M100-S26; CLSI: Wayne, PA, USA, 2016. [Google Scholar]
- Hombach, M.; Jetter, M.; Blöchliger, N.; Kolesnik-Goldmann, N.; Böttger, E.C. Fully automated disc diffusion for rapid antibiotic susceptibility test results: A proof-of-principle study. J. Antimicrob. Chemother. 2017, 72, 1659–1668. [Google Scholar] [CrossRef] [PubMed]
- Parra-Millán, R.; Vila-Farrés, X.; Ayerbe-Algaba, R.; Varese, M.; Sánchez-Encinales, V.; Bayó, N.; Pachón-Ibáñez, M.E.; Teixidó, M.; Vila, J.; Pachón, J.; et al. Synergistic activity of an OmpA inhibitor and colistin against colistin-resistant Acinetobacter baumannii: Mechanistic analysis and in vivo efficacy. J. Antimicrob. Chemother. 2018, 73, 3405–3412. [Google Scholar] [CrossRef]
- Khan, M.A.; Aldebasi, Y.H.; Alsuhaibani, S.A.; Alsahli, M.A.; Alzohairy, M.A.; Khan, A.; Younus, H. Therapeutic potential of thymoquinone liposomes against the systemic infection of Candida albicans in diabetic mice. PLoS ONE 2018, 13, e0208951. [Google Scholar] [CrossRef]
- Khan, S.H.; Younus, H.; Allemailem, K.S.; Almatroudi, A.; Alrumaihi, F.; Alruwetei, A.M.; Alsahli, M.A.; Khan, A.; Khan, M.A. Potential of Methylglyoxal-Conjugated Chitosan Nanoparticles in Treatment of Fluconazole-Resistant Candida albicans Infection in a Murine Model. Int. J. Nanomed. 2020, 15, 3681–3693. [Google Scholar] [CrossRef]
- Maswadeh, H.M.; Aljarbou, A.N.; Alorainy, M.S.; Rahmani, A.H.; Khan, M.A. Coadministration of doxorubicin and etoposide loaded in camel milk phospholipids liposomes showed increased antitumor activity in a murine model. Int. J. Nanomedicine. 2015, 10, 2847–2855. [Google Scholar] [CrossRef] [PubMed]
- Khan, M.A.; Khan, A.; Khan, S.H.; Azam, M.; Khan, M.M.U.; Khalilullah, H.; Younus, H. Coadministration of liposomal methylglyoxal increases the activity of amphotericin B against Candida albicans in leukopoenic mice. J. Drug Target 2020, 6, 1–10. [Google Scholar] [CrossRef]
- Su, X.Z.; Zhang, X.; Chen, Y.; Tomofusa, T. Multiple resistance in Acinetobacter baumannii ATCC 19606 and cloning of genes responsible for the resistance. Chin. J. Antibiot. 2006, 31, 688–691. [Google Scholar]
- World Health Organization. WHO Publishes of Bacteria for Which New Antibiotics are Urgently Needed. Available online: http://www.who.int/mediacentre/news/release/2017/bacteria-antibiotics-needed/fr/ (accessed on 15 August 2019).
- Ayoub, M.C.; Hammoudi, H.D. Insights into Acinetobacter baumannii: A Review of Microbiological, Virulence, and Resistance Traits in a Threatening Nosocomial Pathogen. Antibiotics 2020, 9, 119. [Google Scholar] [CrossRef]
- Goel, S.; Mishra, P. Thymoquinone inhibits biofilm formation and has selective antibacterial activity due to ROS generation. Appl. Microbiol. Biotechnol. 2018, 102, 1955–1967. [Google Scholar] [CrossRef]
- Chaieb, K.; Kouidhi, B.; Jrah, H.; Mahdouani, K.; Bakhrouf, A. Antibacterial activity of Thymoquinone, an active principle of Nigella sativa and its potency to prevent bacterial biofilm formation. BMC Complement Altern. Med. 2011, 11, 29. [Google Scholar] [CrossRef]
- Dera, A.A.; Ahmad, I.; Rajagopalan, P.; Shahrani, M.A.; Saif, A.; Alshahrani, M.Y.; Alraey, Y.; Alamri, A.M.; Alasmari, S.; Makkawi, M.; et al. Synergistic efficacies of thymoquinone and standard antibiotics against multi-drug resistant isolates. Saudi Med. J. 2021, 42, 196. [Google Scholar] [CrossRef]
- Laskar, A.A.; Khan, M.A.; Rahmani, A.H.; Fatima, S.; Younus, H. Thymoquinone, an active constituent of Nigella sativa seeds, binds with bilirubin and protects mice from hyperbilirubinemia and cyclophosphamide-induced hepatotoxicity. Biochimie 2016, 127, 205–213. [Google Scholar] [CrossRef]
- Fahmy, H.M.; Saad, E.A.E.S.; Sabra, N.M.; El-Gohary, A.A.; Mohamed, F.F.; Gaber, M.H. Treatment merits of Latanoprost/Thymoquinone-Encapsulated liposome for glaucomatus rabbits. Int. J. Pharm. 2018, 548, 597–608. [Google Scholar] [CrossRef]
- Mostafa, M.; Alaaeldin, E.; Aly, U.F.; Sarhan, H.A. Optimization and Characterization of Thymoquinone-Loaded Liposomes with Enhanced Topical Anti-inflammatory Activity. AAPS Pharmscitech 2018, 19, 3490–3500. [Google Scholar] [CrossRef]
- Vu, M.N.; Kelly, H.G.; Tan, H.X.; Juno, J.A.; Esterbauer, R.; Davis, T.P.; Truong, N.P.; Wheatley, A.K.; Kent, S.J. Hemagglutinin Functionalized Liposomal Vaccines Enhance Germinal Center and Follicular Helper T Cell Immunity. Adv. Healthc. Mater. 2021, e2002142. [Google Scholar] [CrossRef]
- Yong, Y.S.; Saiful Yazan, L.; Ng, W.K.; Noordin, M.M.; Sapuan, S.; Foo, J.B.; Tor, Y.S. Acute and subacute toxicity profiles of thymoquinone-loaded nanostructured lipid carrier in BALB/c mice. Int. J. Nanomed. 2016, 11, 5905–5915. [Google Scholar] [CrossRef] [PubMed]
- Dimer, F.A.; Pigatto, M.C.; Boque, C.A.; Pase, C.S.; Roversi, K.; Pohlmann, A.R.; Burger, M.E.; Rates, M.K.; Dalla Costa, T.; Guterres, S.S. Nanoencapsulation Improves Relative Bioavailability and Antipsychotic Effect of Olanzapine in Rats. J. Biomed. Nanotechnol. 2015, 11, 1482–1493. [Google Scholar] [CrossRef] [PubMed]
- Badran, M.M.; Alomrani, A.H.; Harisa, G.I.; Ashour, A.E.; Kumar, A.; Yassin, A.E. Novel docetaxel chitosan-coated PLGA/PCL nanoparticles with magnified cytotoxicity and bioavailability. Biomed. Pharm. 2018, 106, 1461–1468. [Google Scholar] [CrossRef]
- Alipour, M.; Suntres, Z.E. Liposomal antibiotic formulations for targeting the lungs in the treatment of Pseudomonas aeruginosa. Ther. Deliv. 2014, 5, 409–427. [Google Scholar] [CrossRef]
- Kobayashi, S.D.; Malachowa, N.; DeLeo, F.R. Neutrophils and Bacterial Immune Evasion. J. Innate Immun. 2018, 10, 432–441. [Google Scholar] [CrossRef]
- Vu, M.N.; Kelly, H.G.; Wheatley, A.K.; Peng, S.; Pilkington, E.H.; Veldhuis, N.A.; Davis, T.P.; Kent, S.J.; Truong, N.P. Cellular Interactions of Liposomes and PISA Nanoparticles during Human Blood Flow in a Microvascular Network. Small 2020, 16, e2002861. [Google Scholar] [CrossRef] [PubMed]
- Tang, J.H.; Gao, D.P.; Zou, P.F. Comparison of serum PCT and CRP levels in patients infected by different pathogenic microorganisms: A systematic review and meta-analysis. Braz. J. Med. Biol. Res. 2018, 51, e6783. [Google Scholar] [CrossRef]
- Marion, C.R.; Lee, J.; Sharma, L.; Park, K.S.; Lee, C.; Liu, W.; Liu, P.; Feng, J.; Gho, Y.S.; Dela Cruz, C.S. Toll-Like Receptors 2 and 4 Modulate Pulmonary Inflammation and Host Factors Mediated by Outer Membrane Vesicles Derived from Acinetobacter baumannii. Infect. Immun. 2019, 87, e00243-19. [Google Scholar] [CrossRef]
- Harris, G.; KuoLee, R.; Xu, H.H.; Chen, W. Acute intraperitoneal infection with a hypervirulent Acinetobacter baumannii isolate in mice. Sci. Rep. 2019, 9, 6538. [Google Scholar] [CrossRef] [PubMed]

| Group | Mortality | Body Weight | ||
|---|---|---|---|---|
| Day 1 | Day 5 | Day 11 | ||
| Vehicle control | 0/8 | 28 ± 2.4 | 28.8 ± 2.2 | 29.2 ± 2.1 |
| Sham liposomes | 0/8 | 27.4 ± 3.0 | 27.7 ± 3.1 | 28.2 ± 3.3 |
| Free TQ—1 mg/kg | 0/8 | 29.6 ± 1.8 | 29.6 ± 2.2 | 30 ± 2.0 |
| Free TQ—10 mg/kg | 0/8 | 28.8 ± 2.5 | 28.7 ± 2.4 | 28 ± 3.4 |
| Free TQ—20 mg/kg | 0/8 | 28.6 ± 2.4 | 28.4 ± 3.6 | 27.8 ± 3.6 |
| Free TQ—40 mg/kg | 0/8 | 28.2 ± 2.2 | 26.5 ± 3.4 | 26.4 ± 3.1 |
| Lip-TQ—1 mg/kg | 0/8 | 26.6 ± 1.7 | 29.2 ± 1.8 | 27.7 ± 1.5 |
| Lip-TQ—10 mg/kg | 0/8 | 28.5 ± 3.8 | 28.6 ± 2.7 | 27.6 ± 2.5 |
| Lip-TQ—20 mg/kg | 0/8 | 29.4 ± 2.6 | 29 ± 3.2 | 28.2 ± 4.0 |
| Lip-TQ—40 mg/kg | 0/8 | 29 ± 3.5 | 28.4 ± 3.0 | 27.8 ± 3.8 |
| Group | Erythrocytes/mm3 × (106) | Leukocytes/mm3 × (103) | Platelets/mm3 × (105) |
|---|---|---|---|
| Vehicle control | 8.44 ± 1.1 | 6.6 ± 2.23 | 4.64 ± 1.12 |
| Sham liposomes | 8.28 ± 1.4 | 6.8 ± 2.52 | 4.46 ± 2.04 |
| Free TQ—1 mg/kg | 8.12 ± 0.92 | 7.1 ± 2.54 | 4.48 ± 1.24 |
| Free TQ—10 mg/kg | 7.88 ± 1.6 | 6.8 ± 1.88 | 4.59 ± 2.10 |
| Free TQ—20 mg/kg | 7.22 ± 0.96 | 6.6 ± 1.92 | 4.2 ± 1.66 |
| Free TQ—40 mg/kg | 6.1 ± 0.76 * | 5.7 ± 1.75 | 3.8 ± 1.62 |
| Lip-TQ—1 mg/kg | 8.76 ± 1.5 | 7.22 ± 1.72 | 4.88 ± 1.78 |
| Lip-TQ—10 mg/kg | 8.26 ± 1.8 | 6.94 ± 1.56 | 4.06 ± 1.63 |
| Lip-TQ—20 mg/kg | 7.52 ± 0.92 | 6.2 ± 2.8 | 4.1 ± 1.92 |
| Lip-TQ—40 mg/kg | 7.33 ± 1.2 | 6.24 ± 2.4 | 4.1 ± 1.66 |
| Group | AST (IU/L) | ALT (IU/L) | BUN (mg/dL) | Creatinine (mg/dL) |
|---|---|---|---|---|
| Vehicle control | 24 ± 4.6 | 32 ± 5.8 | 18 ± 2.8 | 0.46 ± 0.08 |
| Sham liposomes | 26 ± 3.2 | 27.8 ± 6.2 | 22 ± 2.2 | 0.52 ± 0.10 |
| Free TQ—1 mg/kg | 32 ± 2.5 | 28.4 ± 5.2 | 25 ± 2.8 | 0.48 ± 0.12 |
| Free TQ—10 mg/kg | 36 ± 6.6 | 27.8 ± 6.2 | 28 ± 5.1 | 0.55 ± 0.11 |
| Free TQ—20 mg/kg | 48 ± 11.4 | 32.6 ± 6.0 | 32.3 ± 4.8 | 0.64 ± 0.24 |
| Free TQ—40 mg/kg | 69 ± 7.6 ** | 48.8 ± 5.2 * | 34.5 ± 6.6 * | 0.66 ± 0.16 |
| Lip-TQ—1 mg/kg | 22 ± 2.7 | 26.2 ± 5.4 | 21 ± 4.4 | 0.38 ± 0.07 |
| Lip-TQ—10 mg/kg | 27.4 ± 4.2 | 29.4 ± 4.8 | 22 ± 3.8 | 0.47 ± 0.11 |
| Lip-TQ—20 mg/kg | 36.6 ± 7.4 | 34.2 ± 7.6 | 23.6 ± 4.0 | 0.49 ± 0.09 |
| Lip-TQ—40 mg/kg | 47.2 ± 7.8 * | 38.2 ± 7.3 | 25.8 ± 3.8 | 0.58 ± 0.14 |
Publisher’s Note: MDPI stays neutral with regard to jurisdictional claims in published maps and institutional affiliations. |
© 2021 by the authors. Licensee MDPI, Basel, Switzerland. This article is an open access article distributed under the terms and conditions of the Creative Commons Attribution (CC BY) license (https://creativecommons.org/licenses/by/4.0/).
Share and Cite
Allemailem, K.S.; Alnuqaydan, A.M.; Almatroudi, A.; Alrumaihi, F.; Aljaghwani, A.; Khalilullah, H.; Younus, H.; Khan, A.; Khan, M.A. Safety and Therapeutic Efficacy of Thymoquinone-Loaded Liposomes against Drug-Sensitive and Drug-Resistant Acinetobacter baumannii. Pharmaceutics 2021, 13, 677. https://doi.org/10.3390/pharmaceutics13050677
Allemailem KS, Alnuqaydan AM, Almatroudi A, Alrumaihi F, Aljaghwani A, Khalilullah H, Younus H, Khan A, Khan MA. Safety and Therapeutic Efficacy of Thymoquinone-Loaded Liposomes against Drug-Sensitive and Drug-Resistant Acinetobacter baumannii. Pharmaceutics. 2021; 13(5):677. https://doi.org/10.3390/pharmaceutics13050677
Chicago/Turabian StyleAllemailem, Khaled S., Abdullah M. Alnuqaydan, Ahmad Almatroudi, Faris Alrumaihi, Aseel Aljaghwani, Habibullah Khalilullah, Hina Younus, Arif Khan, and Masood A. Khan. 2021. "Safety and Therapeutic Efficacy of Thymoquinone-Loaded Liposomes against Drug-Sensitive and Drug-Resistant Acinetobacter baumannii" Pharmaceutics 13, no. 5: 677. https://doi.org/10.3390/pharmaceutics13050677
APA StyleAllemailem, K. S., Alnuqaydan, A. M., Almatroudi, A., Alrumaihi, F., Aljaghwani, A., Khalilullah, H., Younus, H., Khan, A., & Khan, M. A. (2021). Safety and Therapeutic Efficacy of Thymoquinone-Loaded Liposomes against Drug-Sensitive and Drug-Resistant Acinetobacter baumannii. Pharmaceutics, 13(5), 677. https://doi.org/10.3390/pharmaceutics13050677

